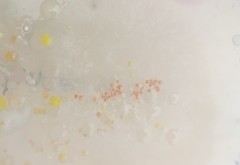
Enterobacteriales

Enterobacteriales: taxon details and analytics
- Domain
- Kingdom
- Bacteria
- Phylum
- Proteobacteria
- Class
- Gammaproteobacteria
- Order
- Enterobacteriales
- Family
- Genus
- Species
- Scientific Name
- Enterobacteriales
Enterobacteriales in languages:
- Chinese
- 腸桿菌目
- English
- enterobacteria and allies
- Thai
- อันดับ แบคทีเรียในลำไส้ และอื่น ๆ